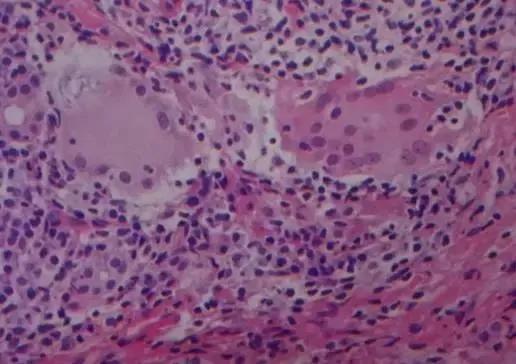
病理报告不会看？别怕，手把手教你

来源:徐州市肿瘤医院
患者或其家属手里拿着病理报告,眉头紧锁,心中有十万个为什么……
我这个报告什么意思?
良性还是恶性?
还需要再切吗?
此处省略一千字……………

针对以上的情况,小编把病理诊断报告中常见的问题做一些归纳。总结如下:
病理报告的基本类型
Ⅰ类:明确和基本明确的病理诊断(需包括取材部位和疾病名称)。
Ⅱ类:不能完全肯定疾病名称和(或)病变性质,或对于拟诊的疾病名称和(或)病变性质有所保留的病理诊断意向,可在拟诊名称前冠以诸如病变“倾向”、“提示”、“可能”、“考虑”、“符合”、“疑为”、“不能排除(除外)”之类的词语。
Ⅲ类:切片上所显示的病变不足以诊断某种疾病时,只能作病变形态的描写。
Ⅳ类:因送检标本过小、破碎、固定不当、自溶、严重机械挤压变形、被烧灼、干涸等,无法做出病理诊断。

病理报告的专业术语
炎症
分为特异性炎症和非特异性炎症,特异性炎症是特定致病因素引起的,报告中会出现“肉芽肿性炎”的诊断结果,如结核,麻风,梅毒及真菌等。具体的致病原需要进一步的检测,如特殊染色(银染、PAS染色)等,以结核为例,一般会“建议抗酸杆菌检测或结核PCR 检测”。
肿瘤
良性肿瘤的一般原则是在策划或细胞名称后面加一个瘤字,英文如腺瘤,平滑肌瘤。
恶性肿瘤的命名是在上皮策划(腺上皮、鳞状上皮等)后加一个癌字,如腺癌、鳞状上皮癌,间叶策划(纤维、血管、脂肪、神经、平滑肌等)的恶性肿瘤则称为肉瘤,如平滑肌肉瘤。
交界性肿瘤,良恶性之间的中间型肿瘤、临界性肿瘤,如卵巢交界性浆/黏液性囊腺瘤。要尽早采取有效的治疗。
大部分带瘤字的都是良性肿瘤,但也有一些叫瘤非瘤的名称,如黄色瘤,动脉瘤,创伤性神经瘤,牙龈瘤,胆脂瘤,错构瘤等。更有些肿瘤,名字看似良性,实际却是恶性,如精原细胞瘤,无性细胞瘤等。有些叫病而是恶性肿瘤的名称,例如白血病,蕈样霉菌病,霍奇金病,鲍温病,派杰病等。还有瘤病,主要指肿瘤的多发状态,如纤维瘤病,血管瘤病,平滑肌瘤病。
级别和分化:高分化的肿瘤是低级别(Ⅰ级),低分化的肿瘤是高级别(Ⅲ级);或分化越低,分级越高,恶性程度越高,而分化越高,分级越低,恶性程度越低。
癌前病变
虽然不是癌,但如果不积极处理,可发展为癌,肿瘤的发生一般经历增生-不(非)典型增生、异型增生、上皮内瘤变(上皮内病变)-癌变的过程,轻度不(非)典型增生、轻度异型增生或低级别上皮内瘤变在去除病因后可以恢复,重度不(非)典型增生、重度异型增生或高级别上皮内瘤变很难逆转,易发展为癌。
原位癌、早期浸润、微浸润
原位癌:黏膜上皮层内或皮肤表皮层内细胞全层癌变,但未突破基底膜。是一种早期非浸润性癌,早期临床表现不明显,早发现治愈率很高。
早期浸润、微浸润:为原位的进一步发展,是指肿瘤策划突破基底膜的范围局限于某个深度或宽度。不同的癌策划对早期浸润、微浸润的范围不同。
例如:宫颈癌策划,早期浸润指突破基底膜深度不超过3mm,宽度不超过7mm,乳腺癌是不超过1mm,肺癌是不超过5mm,卵巢癌不超过5mm。

病理报告的某些建议
1)建议抗炎治疗后复查:一般用于炎症较重的病变,患者需结合临床其他检查,同时听取临床医师的意见进行相应的抗炎治疗后继续复查以排除其他可疑肿瘤性病变。
2)建议(正在行)免疫组化检测:此检测一为明确诊断,二为疾病诊疗。如患者标本送至本科室病理科则无需病人再取标本,可直接记费(住院病人)或门诊缴费后行此检测;如是会诊标本则需至原单位借蜡块或切白片(未经染色的标本切片,根据免疫组化标记的个数确定切几张)至本科室行免疫组化检测。在没有特殊原因的情况下一般需要1周左右出报告。

3)建议Fish检测:即荧光原位杂交技术(fluorescence in situ hybridization),简称FISH。是利用荧光标记的特异核酸探针与细胞内相应的靶DNA分子或RNA分子杂交,通过在荧光显微镜或共聚焦激光扫描仪下观察荧光信号,来确定与特异探针杂交后被染色的细胞或细胞器的形态和分布,或者是结合了荧光探针的DNA区域或RNA分子在染色体或其他细胞器中的定位。一般用于乳腺癌、肠癌、胃癌及淋巴瘤等,与临床分子靶向治疗相关。外院会诊需要提供蜡块或白片。在没有特殊原因的情况下一般需要1周左右出报告。
4)建议错配修复蛋白检测:多用于肠癌、胃癌、胰腺癌、子宫内膜癌等,本科室常规做的一般是肠癌及胃癌,即通过免疫组化检测MLH1、MSH2、MSH6及PMS2蛋白。外院会诊需要提供蜡块或白片。
5)建议结核PCR检测:PCR技术在结核病诊断中具有敏感性高、特异性强、快速等优越性,对结核的诊断与鉴别诊断有独特作用。选坏死区域多的蜡块或白片。
6)建议T系或B系基因重排:基因重排技术用于体外检测淋巴瘤或淋巴增生的发生,鉴定良性增生与B细胞,T细胞淋巴瘤,并进行预后及复发的监测和评估。在淋巴策划非典型增生及形态学、免疫组化染色结果不典型的淋巴瘤的诊断中优势明显。

注意
病理:
病理专业博大精深,涉及全身所有系统,大至器官,小至分子,小编在此仅做简单归纳,在治疗上如有疑问还需请教专业医生。
